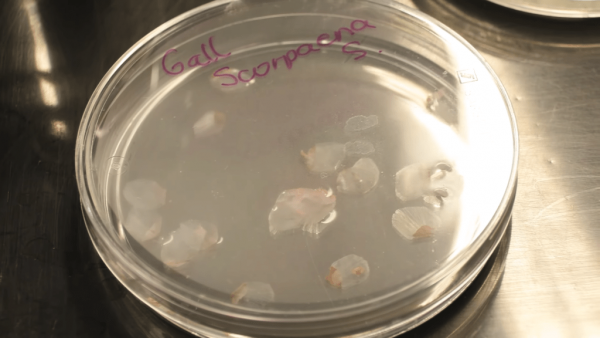
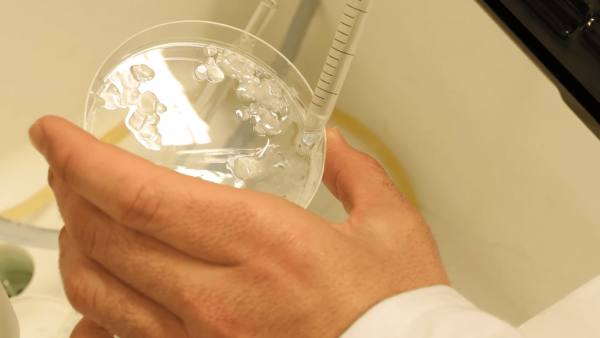

眼角膜嚴重受損難以修復,需依賴器官捐贈移植,有機會延誤治療時機。西班牙有研究團隊利用街市常見魚類的魚鱗,研發出具高度生物相容性的人工角膜,有望成為傳統捐贈移植的「平替」方案。新技術不僅成本大降、材料易得,更有潛力帶動漁業發展。
角膜損傷難自癒 傳統移植受限捐贈
眼角膜是眼睛前方的透明組織,用以保護眼球及聚焦光線;由於角膜缺乏血管,再生能力有限,一旦嚴重受損便難以自行修復。目前治療嚴重角膜疾病的主要方法是角膜移植手術治療,但器官捐贈來源有限,患者往往需要長時間輪候,錯失黃金治療時機。
 科學家表示,他們成功從鯉魚等多種常見食用魚類的鱗片中,提取出高品質膠原蛋白,製成人工角膜植入物。(圖:UGR)
科學家表示,他們成功從鯉魚等多種常見食用魚類的鱗片中,提取出高品質膠原蛋白,製成人工角膜植入物。(圖:UGR)
人工角膜具有「高度生物相容性、透明度高、耐用性強」。(圖:UGR)
人工角膜具有「高度生物相容性、透明度高、耐用性強」。(圖:UGR)
 魚鱗來源極易取得、成本低廉,同時有望促進漁業發展。(圖:UGR)
魚鱗來源極易取得、成本低廉,同時有望促進漁業發展。(圖:UGR)
這項技術距離實際應用於人體仍有漫長道路,須通過嚴謹的人體臨床試驗,驗證安全性與有效性。(圖:UGR)
這項技術距離實際應用於人體仍有漫長道路,須通過嚴謹的人體臨床試驗,驗證安全性與有效性。(圖:UGR)
 雖然常見器官移植通常效果良好,但有必要開發有效再生方法,不依賴器官捐獻,縮短排隊等候時間。(圖:UGR)
雖然常見器官移植通常效果良好,但有必要開發有效再生方法,不依賴器官捐獻,縮短排隊等候時間。(圖:UGR)
西班牙格拉納達大學組織工程研究團隊與生物醫學研究所科學家表示,他們成功從鯉魚等多種常見食用魚類的鱗片中,提取出高品質膠原蛋白,製成人工角膜植入物。人工角膜優勢︰
- 高度生物相容性
- 透明度高
- 耐用性強
街市魚鱗變身救命材料 有望解捐贈之困
研究團隊對魚鱗材料進行詳細分析,證實其具備修復和再生角膜的潛力。隨後進行的動物實驗中,植入魚鱗人工角膜的受試動物表現出良好的功能恢復。研究共同作者、格拉納達大學組織學教授Ingrid Garzon指出:「魚鱗來源極易取得、成本低廉,同時有望促進本地漁業發展。」
研究團隊選用市場常見魚類的魚鱗,將原本被視為廢棄物的材料化身為具醫療價值的資源。另一位組織學教授Miguel Alaminos補充:「傳統角膜移植雖然效果理想,但依賴器官捐贈始終受限於輪候制度。我們迫切需要開發不依賴捐贈的有效再生方法。」
何時可用於人體?尚待臨床試驗
研究團隊表示,實驗室測試及動物實驗均顯示,魚鱗人工角膜在功能上表現良好,接受植入的動物未出現明顯排斥反應。然而,這項技術距離實際應用於人體仍有漫長道路,必須先通過嚴謹的人體臨床試驗,驗證其安全性與有效性。其實早在2016年,安特衛普大學研究人員發表的同儕審核論文已證實,魚鱗衍生的人工角膜與人體具有生物相容性,為後續研究奠定重要基礎。
資料來源:西班牙格拉納達大學、REUTERS
T10
